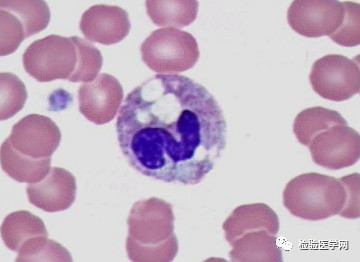

- 人造血,你敢用吗?人造血Vs爱心血!
0评论2019-05-24

- 疯狂的幽门螺旋杆菌,已感染8亿中国人!想预防看这里!
0评论2019-05-23

- 医学检验资格考试必背知识点--临床检验基础
0评论2019-05-14

- 权威解读:中国首个SAA专家共识在儿科中的临床应用
0评论2019-04-15
- 细胞的自白书,你记住我了吗?
0评论2019-04-10

- 20分钟内完成心梗三项检测,山东省立医院是这么做的!
0评论2019-04-04

- 中国首个《血清淀粉样蛋白A在感染性疾病中临床应用的专家共识》正式发布
0评论2019-03-21

- 未来质谱如何发展?全自动临床质谱一站式解决方案重磅发布
0评论2019-03-20

- 完美解读TORCH筛查,警惕这9大认识误区!
0评论2019-03-19

- 区域检验中心招标项目被举报?!市场监督管理局介入调查!
0评论2019-03-18

- 2019年度白求恩精神研究会检验医学大会第二轮通知
0评论2019-03-07

- 安图大学成立仪式暨安图大学郑州论坛(第一届)隆重举行
0评论2019-03-03

- 关于唐氏筛查的疑问和困惑,这篇解释的最清楚了
0评论2019-02-25

- 肾功四项“三高一低”,咋回事?
0评论2019-02-18

- 血脂化验单没有“上下箭头”,也不一定代表健康哦!
0评论2019-02-13

- 【详解】特种蛋白项目的临床应用
0评论2019-02-01

- 离奇的高血糖
0评论2019-01-31

- 孕育杀手?HPV又惹上了“官司”!
0评论2019-01-24

- 体检单上的某些指标,原来暗示着这些病!3分钟教你全看懂!
0评论2019-01-23

- 临床检验项目自动审核系统,开创“智慧实验室”新时代
0评论2019-01-08